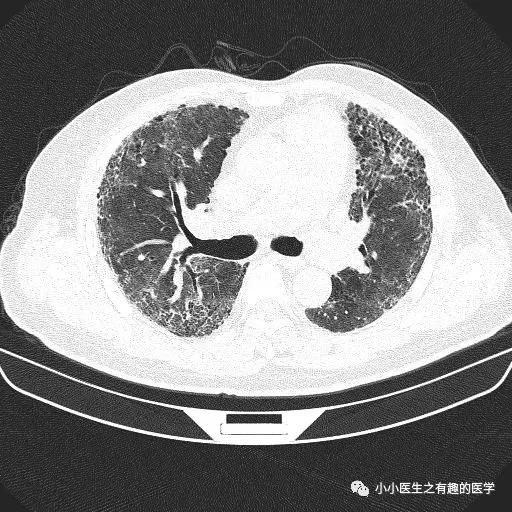
间质性肺炎CT诊断,间质性肺炎ct诊断报告

经典
前言 有网友留言,谈谈间质性肺炎。那就先说说间质性肺炎的经典改变。
网格 ≈ 间质性肺炎
网
间质性肺炎的影像学表现,复杂的很复杂,有时候和肺炎不容易区分。
经典的间质性肺炎,就是一张网!


经典的间质性肺炎
1.胸膜下2.网格状很多间质性肺炎,都有这个特征,是间质性肺炎的入门知识,也是很重要的知识。
1

乌漆嘛黑的是肺气肿。
间质性肺炎 合并 肺气肿



注意
1.别把典型的间质性肺炎,误诊为肺炎。抗生素的狂轰滥炸,毫无作用。 2.间质性肺炎,谨慎支气管镜检查。支气管镜对肺是一次打击。正常的肺,可以对抗这次打击。间质性肺炎,原本脆弱,有可能急性加重。
怎么治疗
不好治疗。 间质性肺炎,特别是“特发性肺纤维化”,就和这首歌一样,“情网情网最难闯”,不好治疗。1.治疗病因。2.其他。现在有很多新药,可一试。也不要悲观。
间质性肺炎


假如一个患者结缔组织病,双肺多发病变,但是,胸膜下没有病灶,首先不考虑间质性肺炎,要考虑其他疾病。